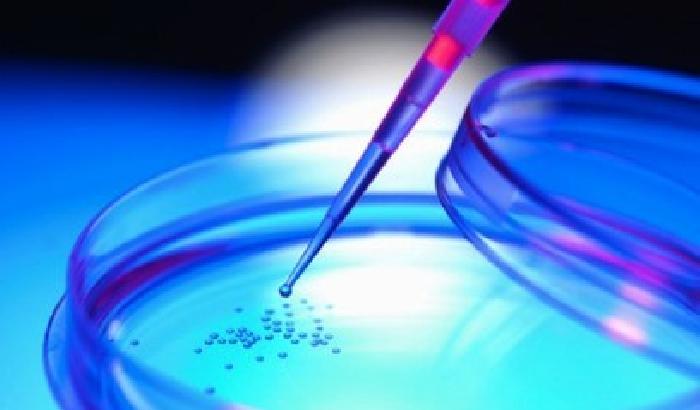
No al metodo Stamina per Noemi

ATF AMP
Ancora un no al metodo Stamina per la bimba di 18 mesi, Noemi, “l’amica di Papa Francesco”. Il giudice del lavoro dell’Aquila ha rigettato il ricorso per l’accesso alla cura.
Il no arriva dopo gli altri due dei giudici di Chieti. «Una doccia fredda», ha detto il papà della bambina abruzzese di Guardiagrele (Chieti), da ieri in ospedale.
Si dice «molto provata», l’avvocato della famiglia, Michela Di Iorio. Per la decisione sembrerebbe sia stata seguita la linea del Comitato scientifico.
[GotoHome_Torna alla Home]